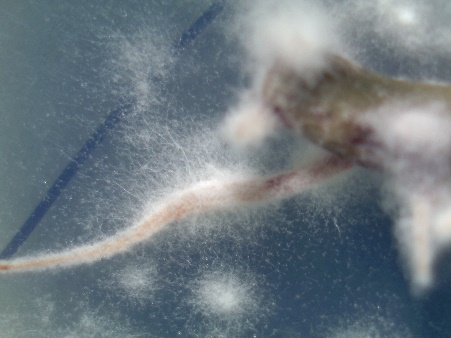

(via TheNewswire)
Mississauga, ON Canada and Sacramento, CA USA (May 15, 2024) – TheNewswire – Bee Vectoring Technologies International Inc. (the “Company” or “BVT”) (CSE: BEE) (OTCQB: BEVVF) (CVE:BEE) is pleased to announce significant Research and Development advancements for its proprietary biological control agent Clonostachys rosea strain CR-7 (CR-7) use as a seed treatment solution for soybeans. This breakthrough underscores the product’s compatibility and safety on seeds, propelling it toward commercialization in the agriculture sector.
“Investing in this research is crucial for understanding the potential market for a CR-7 seed treatment product,” said Ashish Malik, CEO of BVT. “This study allowed us to assess the effectiveness and safety of CR-7 on soybean seed, duration of action, and compatibility with other treatments. These are fundamental studies to support launching this product and further advancing our partnership opportunities.”
“Two years of rigorous testing confirmed CR-7’s exceptional safety profile on soybean seeds, showing no signs of toxicity or adverse effects on plant health,” said Dr. Mason Newark, Field Technical Manager at BVT. “These results establish CR-7 as an excellent candidate for seed treatment, given its long shelf life, compatibility with other common seed treatment products, and its safety for use on seeds.”
The seed treatment market is a significant new revenue opportunity for the Company. Through a future licensing agreement, BVT could potentially reap significant annual royalties from this application.
“We continue to progress our collaborations with major global multinationals,” said Mr. Malik. “These are potential partners looking to differentiate their seed treatment portfolio offerings in soybeans, a major global crop that is worth US$155 billion annually and projected to reach US$278 billion by 2031.” (1)
Research highlights include:
Extended Viability: CR-7 demonstrates a long shelf life once it is coated on soybean seeds. This is a key metric for seed treatments since seeds may not be planted for 6-12 months post-treatment, thus giving BVT sales partners a strong value proposition and a robust product. This shelf-life study in ongoing.
Compatibility with other seed treatments: Testing confirms CR-7's compatibility with other seed treatment products, including biologicals and chemical pesticides, ensuring it fits seamlessly into existing agricultural practices where multiple products are applied to the seed at the same time.
Additional observations from BVT’s R&D team included:
“Our ongoing R&D efforts continue to showcase the robustness of CR-7, with promising results indicating its effectiveness remains intact for up to nine months and potentially beyond,” continued Dr. Newark. “Now we are testing for 20 months plus viability. What we’ve found so far that’s particularly exciting is that CR-7 grows with the plant and creates a broader zone of protection from the seed stage to well into the roots and stems of the plant.”

Above: A blotter test can be used to detect CR-7. The photos show that CR-7 is growing on soybean root and stem tissue.
Soybeans are the fourth leading crop produced globally. Brazil is the world’s largest soybean producer and exporter and together with the United States, the two countries supply nearly 90 percent of soybean exports to the world. (2)
What’s next? A commercial formulation of the seed treatment product is in development: BVT is now focused on taking this strong proof of concept and turning it into a formulated product.
(1) Source: IISD, Global Market Report: Soybean prices and sustainability, 2024
(2) Source: USDA, Economic Research Service, 2023
About Bee Vectoring Technologies International Inc .
BVT, an agriculture technology company, is a market disruptor with a significant global market opportunity in the $240 billion crop protection and fertilizer market. BVT has pioneered a natural precision agriculture system that replaces chemical pesticides and wasteful plant protection product spray applications by delivering biological pesticide alternatives to crops using commercially grown bees. BVT’s award-winning technology, precision vectoring, is completely harmless to bees and allows minute amounts of naturally-derived pesticides (called biologicals) to be delivered directly to blooms, providing improved crop protection and yield results than traditional chemical pesticides – and improving the health of the soil, the microbiome and the environment. Currently, BVT has over 55 granted patents, many more patents pending in all major agricultural countries worldwide and has US EPA registration of its Vectorite™ with CR-7 (EPA Registration No. 90641-2) for sale as a registered biological fungicide for use on the labeled crops.
Additional information can be viewed at the Company’s website www.beevt.com . To receive regular news updates from the Company, subscribe at www.beevt.com/newsletter .
BVT Company Contact:
Ashish Malik, President & CEO, BVT
info@beevt.com
BVT Investor Contacts:
Babak Pedram
Virtus Advisory Group
Tel: 416-646-6779
bpedram@virtusadvisory.com
The CSE has neither approved nor disapproved the contents of this press release. The CSE does not accept responsibility for the adequacy or accuracy of this release. Certain statements contained in this press release constitute "forward-looking information" as such term is defined in applicable Canadian securities legislation. The words "may", "would", "could", "should", "potential", "will", "seek", "intend", "plan", "anticipate", "believe", "estimate", "expect" and similar expressions as they relate to the Company, “annual revenue potential”, are intended to identify forward-looking information. All statements other than statements of historical fact may be forward-looking information. Such statements reflect the Company’s current views and intentions with respect to future events, and current information available to the Company, and are subject to certain risks, uncertainties and assumptions, including: planted acres, selling price of competitive chemical pesticides and the US to Canadian dollar exchange rate. Material factors or assumptions were applied in providing forward-looking information. Many factors could cause the actual results, performance or achievements that may be expressed or implied by such forward-looking information to vary from those described herein should one or more of these risks or uncertainties materialize. These factors include changes in law, competition, litigation, the ability to implement business strategies and pursue business opportunities, state of the capital markets, the availability of funds and resources to pursue operations, new technologies, the ability to protect intellectual property rights, the ability to obtain patent protection for products, third-party intellectual property infringement claims, regulatory changes affecting products, failing research and development activities, the ability to reach and sustain profitability, dependence on business and technical experts, the ability to effectively manage business operations and growth, issuance of debt, dilution of existing securities, volatility of publicly traded securities, potential conflicts of interest, unlikelihood of dividend payments, the potential costs stemming from defending third-party intellectual property infringement claims, the ability to secure relationships with manufacturers and purchasers, as well as general economic, market and business conditions, as well as those risk factors discussed or referred to in the Company’s Filing Statement dated August 14,2020, filed with the CSE and securities regulatory authorities in certain provinces of Canada and available at www.sedar.com. Should any factor affect the Company in an unexpected manner, or should assumptions underlying the forward-looking information prove incorrect, the actual results or events may differ materially from the results or events predicted. Any such forward-looking information is expressly qualified in its entirety by this cautionary statement. Moreover, the Company does not assume responsibility for the accuracy or completeness of such forward-looking information. The forward-looking information included in this press release is made as of the date of this press release and the Company undertakes no obligation to publicly update or revise any forward-looking information, other than as required by applicable law. All figures are in Canadian dollars.
Copyright (c) 2024 TheNewswire - All rights reserved.
© 2026 Canjex Publishing Ltd. All rights reserved.